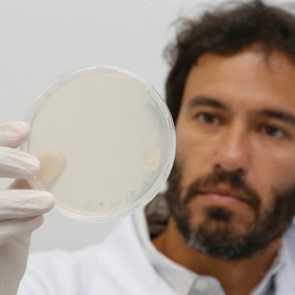
Найдено лекарство против опасных проблем с сердцем

В Киеве подожгли третий за неделю магазин Roshen 0
21 марта 2019 - Marishka
| 856 просмотров
Читать далее...
Россия снова отбомбилась по джихадистам в сирийском Идлибе 0
21 марта 2019 - Marishka
| 887 просмотров
Читать далее...
Ядерный бомбардировщик США полтора часа летал у границ России 0
19 марта 2019 - Marishka
| 866 просмотров
Читать далее...
Родным жертв разбившегося в Эфиопии «Боинга» вместо тел выдали землю 0
18 марта 2019 - Marishka
| 894 просмотра
Читать далее...
Северная Корея разочаровалась в ядерных переговорах с США 0
15 марта 2019 - Marishka
| 870 просмотров
Читать далее...
Найдено лекарство против опасных проблем с сердцем 0
14 марта 2019 - Marishka
| 944 просмотра
Читать далее...
В России назвали «реальную угрозу» от США 0
13 марта 2019 - Marishka
| 952 просмотра
Читать далее...
Россию назвали «проигравшей военной сверхдержавой» 0
12 марта 2019 - Marishka
| 953 просмотра
Читать далее...
Россия тайно разбомбила демилитаризованный Идлиб 0
11 марта 2019 - Marishka
| 902 просмотра
Читать далее...